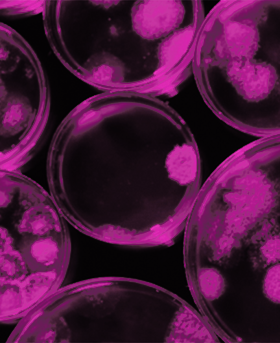
A collection of petri dishes growing micro-organisms

A history of the Microbiology Society
The Microbiology Society, previously named the Society for General Microbiology, was formally established in February 1945, with Sir Alexander Fleming becoming its first President. We look back on how the Society was formed and other milestones that have led us to become one of the largest microbiology societies in Europe with a worldwide membership based in universities, industry, hospitals, research institutes and schools.
Our history
Foundation
The foundation of the Microbiology Society (formerly known as the Society for General Microbiology) was laid at an Annual General Meeting of the Society for Applied Microbiology (previously known as The Society of Agricultural Bacteriologists) on 9 September 1943.
It was at this meeting that the committee realised that there was a lack of contact between various specialisations in microbiology which tended to impede the development of science. It was decided that the time had come to promote the advancement of microbiology by forming a Society that would provide common meeting ground for those working in the various specialised fields.
Image: Delegates who attended the Second International Congress of Microbiology held from 25 July–1 August 1936 at University College London, UK.
Image credit: Wellcome Collection, the Society for General Microbiology archives.

Key people
Some of the key people most active in the organisation of the preliminary meetings were Dr Leslie Alfred Allen, a dairy bacteriologist and President of the Society of Agricultural Bacteriologists and Dr Ralph St John-Brooks.
They had the enthusiastic support of eminent scientists including medical bacteriologists Sir John Ledingham, Sir Paul Fildes, Ashley Miles and Sir Alexander Fleming; bacterial nutritionist Bert Cyril James Gabriel ‘Gabe’ Knight; protozoologist Muriel Robertson; industrial microbiologist Henry J ‘Bill’ Bunker; soil microbiologist Henry Gerard Thornton, virologists Sir Christopher Andrewes, Kenneth Manley Smith; and above all, Marjory Stephenson, one of Britain’s most distinguished bacteriologists. It was Marjory Stephenson who gave the Society its name.
Image: Includes founding members of the Society for General Microbiology, pictured in the front row at the Second International Congress of Microbiology in 1936. These include Leslie Alfred Allen, Ralph St John-Brooks and Muriel Robertson.
Image credit: Wellcome Collection, the Society for General Microbiology archives.

Inauguration
The Society for General Microbiology came into being, inaugurated at a gathering of the Original Members at the London School of Hygiene & Tropical Medicine on 16 February 1945. Sir Alexander Fleming was elected as the Society’s first President and the Society had 241 members.
By the late 1940s and early 1950s there was an impressive advance in microbiological knowledge. Ion-exchange chromatography was developed, revolutionising preparative biochemistry. Atomic research, radio-isotypes became widely available and easy to handle and biochemicals of reasonable purity began to be available commercially.
Image: Sir Alexander Fleming.
Image credit: Wellcome Collection, the Society for General Microbiology archives.

1951–1960
The Journal of General Microbiology
When the Society was founded, the inaugural members knew that there was a considerable backlog of British research that was yet to be published because of the Second World War.
A proportion of this dealt with microbes and they realised that a new journal on general microbiology, would provide a timely outlet for such research. This would also bring papers on fundamental microbiology together and promote the original objective of the Society which was to bring microbiologists together into a broad scientific community. Hence, in 1947, Volume 1 Part 1 of The Journal of General Microbiology was printed by the Cambridge University Press.
Image: Volume I issue of the Journal for General Microbiology, published in 1947.

1951–1960
The Marjory Stephenson Memorial Lecture
Marjory Stephenson was unanimously elected as the second President of the Society in 1947 and following her death in 1947, the Society Committee decided she should be commemorated as both a founding member of the Society and a pioneer of microbial biochemistry.
Thus, the first of the Society’s named lectures came into being by soliciting subscriptions and by 1953, sufficient funds had been accumulated to finance the Marjory Stephenson Memorial (now Prize) Lecture. The prize is awarded to individuals that have made exceptional contributions to the discipline of microbiology.Image: Marjory Stephenson.
Image credit: Wellcome Collection, the Society for General Microbiology archives.

1961–1970
The Journal of General Virology
By 1965 a group of virologists within the Society felt that there was a need for a specialised outlet in their subject area. Council agreed to form a sub-Committee to discuss this further and the first issue of The Journal of General Virology appeared in 1967 and was edited by Professor Peter Wildy and Professor Colin Kaplan.
By the end of the 1960s, it was becoming clear that the journals had grown to a size where they could no longer be produced by the scientific editors and their secretaries alone. There was also an increasing need to seek professional support to help aid the volume of Committee business and a decision was made to set up an independent editorial office with paid staff to support the scientific editors. This move strongly influenced the decision of the Society to purchase its first premises, from the Institute of Biology at their London offices.In 1967 these staff moved to offices at the Biochemical Society offices.
Image: Volume I of The Journal of General Virology, published in 1967.

1961–1970
Establishing Council
The Society’s Committee had been the sole administrative structure for several years following the Society’s foundation. It had two tiers comprising twelve Elected Members – elected by the Society’s membership – plus six Officers (the President, Treasurer, Meetings Secretary, General Secretary and two Editors of The Journal for General Microbiology). Over a period of time, further officer posts were created to handle specific functions and the Committee was renamed the Society for General Microbiology Council in 1962.
Council is responsible for the governance of the Society and normally consists of up to 15 members. Of these, six members are elected by members of the Society and nine are appointed by Council: six as Chairs of Committees, plus the President, General Secretary and Treasurer.
Image: Photo featuring some of the Society's Staff and Council members outside the Society's Harvest House Offices in Reading.

1961–1970
Celebrating the first 25 years
The Society became a registered charity in 1969, to ensure the effective use of its growing income in support of its charitable purpose of 'advancing the art and science of microbiology'.
In 1970 the Society reached its first quarter century and consisted of approximately 2,900 members. At this point, the need for more extensive offices was becoming ever more pressing, and in 1971 the Society purchased its first headquarters building, Harvest House, in Reading. The office was within easy reach of London, had good transport connections nationally and internationally.Image: A garden view photo of Harvest House, the Society for General Microbiology's headquarters from 1971–1991.

1971–1980
The Fleming Prize Lecture
This decade saw the introduction of the Fleming Lecture in 1976, which was established and named after the Society’s first President, Sir Alexander Fleming. The Fleming Prize Lecture recognises early career microbiologists that have achieved an outstanding research record within 12 years of completing their PhD.
Since the award was instituted, 44 early career microbiologists have been recognised, many of whom have gone on to achieve distinguished careers, honours and in one case (Sir Paul Nurse FRS) a Nobel Prize.Image: Sir Alexander Fleming pictured in his laboratory in St Mary's University, London in 1925.
Image credit: Wellcome Collection.

1991–2000
A new location and modernising Microbiology
The continued growth of the Society and its affairs meant that the Society headquarters, at Harvest House, had become too small. In 1991, the Society purchased Marlborough House, in a village seven kilometres south of Reading town centre.
In 1994, the Journal of General Microbiology was relaunched with a modernised format, and it’s title was changed to Microbiology. On-screen editing was introduced in the Editorial Office in the mid-1990s.
Image: Branding used for the journal of Microbiology today.
Image credit: iStock/ClaudioVentrella

1991–2000
The Society’s Golden Jubilee
In 1995, the Society celebrated its Golden Jubilee. In addition to a jubilee edition of SGM Quarterly, a dinner was held at the Spring Meeting that year in Bath. Over 1,000 microbiologists attended the event and Professor Harry Smith delivered a lecture entitled The State of Studies on Bacterial Pathogenesis.
In addition to the Golden Jubilee celebrations, Council asked one of its most distinguished members, former President John Postgate to write an extended version of the history of the Society, entitled Society for General Microbiology - Fifty Years On to mark the occasion.Image: Pictured attending the Golden Jubilee celebrations are: Professor Anthony (Tony) Trinci, Society President at the time, Professor Lorna Casselton FRS and Sir Paul Nurse FRS, followed by Dave Roberts, Pam Hunter and Martin Collins.

1991–2000
International Journal of Systematic and Evolutionary Microbiology
In 1998, the Society took over from the American Society for Microbiology as publisher of the International Journal of Systematic and Evolutionary Microbiology on behalf of the International Committee on Systematic Bacteriology (now the International Committee on Systematics of Prokaryotes) and the Bacteriology and Applied Microbiology Division of the International Union of Microbiological Societies.
The journal is the leading forum for the publication of novel microbial taxa and the International Committee on Systematics of Prokaryotes’s official journal of record for prokaryotic names. It welcomes high-quality research on all aspects of microbial evolution, phylogenetics and systematics, encouraging submissions on all prokaryotes, yeasts, microfungi, protozoa and microalgae across the full breadth of systematics.
Image: Branding used for the International Journal of Systematic and Evolutionary Microbiology.
Image credit: Thinkstock

2001–2010
Journal of Medical Microbiology
In 2004 the Journal of Medical Microbiology was first published by the Society. It was previously produced by The Pathological Society of Great Britain and Ireland. The journal focuses on medical, dental and veterinary microbiology, and infectious diseases from laboratory research to clinical trials, including bacteriology, virology, mycology and parasitology.
Image: Branding used for The Journal of Medical Microbiology.
Image credit: Thinkstock

2001–2010
The Peter Wildy Prize Lecture
The Peter Wildy Prize Lecture was established in 2001. The Peter Wildy Prize Lecture has been awarded annually to recognise an outstanding contribution to microbiology education and/or communication in order to stimulate interest and understanding in the subject.
Image: Peter Wildy.

2001–2010
Sir Howard Dalton Young Microbiologist of the Year Competition
In 2009 the Young Microbiologist of the Year competition was renamed the Sir Howard Dalton Young Microbiologist of the Year Competition in honour of the former President.
The prize recognises and rewards excellence in science communication by a Microbiology Society member who is a postgraduate student or postdoctoral researcher, having gained their PhD in the last two years.
Image: Sir Howard Dalton.

2011–2020
Moving to London
The Society began to realign its paper and print systems moving towards online processes with a review of its publishing activities and the launch of a series of websites, a blog, a podcast and social media channels.
In 2013 the first Annual Conference was held to replace the annual spring and autumn meetings.
In 2014 the Society moved from Marlborough House in Reading to Charles Darwin House in London to be part of a bio hub with six other learned societies to aid collaboration. In 2019 the Society moved to its current offices in Meredith Street London.
Image: Inside the Microbiology Society's offices in Meredith Street.

2011–2020
The Society changes its name and brand
In 2015 the Society for General Microbiology changed its name to the Microbiology Society and rebranded its visual identity.
The Society launched a series of projects to help put microbiology on the agenda including a policy statement on sexually transmitted infections at the House of Commons in 2014, the Antibiotics Unearthed Citizen Science project (2014-2018) to help increase the understanding of antibiotic resistance, a microbiome research report published in 2017 and a review of its open access policy in 2015 and 2018.
Image: The new Microbiology Society logo.

2011–2020
JMM Case Reports, Microbial Genomics, Access Microbiology
A new journal, JMM Case Reports, was launched in 2014, which was a venue for publication of medical, dental and veterinary microbiology case reports. The case studies are later incorporated into Access Microbiology in 2019.
In 2015 Microbial Genomics was launched by the Society. Microbial Genomics is the open access journal of choice for pioneering research in genomics.
Access Microbiology was launched in 2019 to allow members of our community to publish replication studies, negative or null results, research proposals, data management plans, additions to established methods, and interdisciplinary work.
A new publishing platform is put in place to meet the needs of an ever-changing publishing landscape.
Image: Branding used for the new publishing platform.
Image credit: Dennis Kunkel/Science Photo Library

2011–2020
Professional development and early career microbiologists
A full grants review took place in 2016 to ensure Society funding opportunities work to support the professional development of our members.
The Microbiology in Society Award launched in 2016.
The Early Career Microbiologists’ (ECM) Forum was introduced, now known as the Early Career (EC) Forum, at the beginning of 2016 and the first Early Career Microbiologists’ Summer Conference took place in 2018.
Image: ECM Summer Conference 2018 image.
Image credit: iStock/millann

2020
Celebrating 75 years of the Society
In 2020 we recognised 75 years since our founding by Sir Alexander Fleming, Marjory Stephenson and other visionary microbiologists. They knew that providing a common meeting ground for scientists working in specialised fields through the formation of a new society would advance and promote microbiology. In our 75th year a bigger spotlight could not have been thrown on the discipline than the emergence of a novel virus – SARS-CoV-2, causing COVID-19 and the resulting pandemic.
In 2020 our ability to bring groups of microbiologists together for knowledge exchange and to forge new collaborations was especially valuable. We established the first online meeting for researchers in the virology community working on SARS-CoV-2, with the aim of building a research community to coordinate efforts against the pandemic. We also called upon our network to provide the expertise needed to get the first Lighthouse Lab up and running, and our members helped populate COVID-19 testing facilities throughout the year.

2021
Publish and Read
In 2021, as we continued our journey towards Open Access, we signed up the first institutions to our innovative Publish and Read model, allowing a fee-free way for authors to publish Open Access (OA) articles in all of the Society’s journals. We now have hundreds of participants in Publish and Read – serving a range of institutions all over the world.
Our founding journal, Microbiology, celebrated 75 years of publishing in 2021. It has published over 20,000 articles from authors across the world and, as we look to the future, publishing high-quality, rigorously reviewed articles will remain at the core of the journal.

2022
Launch of our innovative open research platform, Access Microbiology
In 2022 we launched our innovative open research platform, Access Microbiology, which provides completely transparent peer review of the widest possible range of microbiology, including negative results, replication studies, policy and pedagogy. We also launched the Members Panel, bringing together members who belong to communities that had previously been underrepresented or marginalised, as we continue to amplify the voices of our members wherever they are in the world, empowering them to embed the benefits of microbiology within wider society.
2023
Knocking Out AMR
As our strategy states, microbiologists are involved in addressing challenges that include urgent global problems. One such challenge is antimicrobial resistance (AMR) and in 2023 we launched ‘Knocking Out AMR’ – an ambitious, bold project designed to promote feasible and effective solutions to AMR through cross-disciplinary and multi-sector collaboration worldwide. This project is an extensive scheme of work aiming to promote feasible and effective solutions to AMR, recognising that microbiologists in academic, industrial and clinical settings worldwide are at the forefront of developing innovative solutions to tackle the problem.
As a not-for-profit publisher we continued to demonstrate why and how publishing with the Society benefits the wider microbiology community – helping us achieve a world in which the science of microbiology provides maximum benefit to society. The income generated from our journals is returned to support activities which benefit our community, including our rich and varied programme of events, grants and professional development.

2024
Changes to our Governing body
To ensure that the Society draws on a sufficiently wide range of expertise for its future decision-making as the environment in which it operates changes dramatically, Council approved a special resolution to be brought forward at the Society’s Annual General Meeting in October 2024. Carried by the membership, this allowed amendment of the Society’s Articles of Association, which are its governing constitution. The amended Articles, approved by the UK’s Charity Commission, allowed the Society to change its governing body to incorporate two groups, a Board of Directors and Trustees and an Advisory Council.
The Board of Trustees is comprised of the Society’s three Executive Officers (President, General Secretary and Treasurer) and three elected members, plus up to three external experts. The role of the Board is to govern the organisation provide the strategic direction of the Society and ensure its long-term financial sustainability.
The Advisory Council is comprised from the Society membership and provides the strategic direction of the Society and is responsible for its governance and financial sustainability.

2025
Celebrating 80 years of the Society
80 years ago in 1945 the Microbiology Society was founded by its first members including Ralph St John Brookes, Muriel Roberts, Marjory Stephenson, Alexander Fleming and many other visionary microbiologists.
Their purpose in forming the Society holds true to this day. Our ability to bring groups of microbiologists together for knowledge exchange and to forge new collaborations remains essential to the Society’s role – to help unlock and harness the unique breadth and depth of our members knowledge about the discipline of microbiology.
In our 80th year we recognise the importance of community, of legacy and look forward to our future – to continue to grasp opportunities to amplify our members’ voices and advance the understanding of microbiology in resolving global challenges.
At the Microbiology Society we have both the heritage and the ambition to bring together our networks and drive forward solutions to those challenges. We need to support more microbiologists to focus on the research that will help solve these grand challenges to the benefit of everyone – in 2025 we call on our members to continue to get involved, to publish for their community and to donate to our fundraising activity, helping us support microbiologists for the next 80 years.

